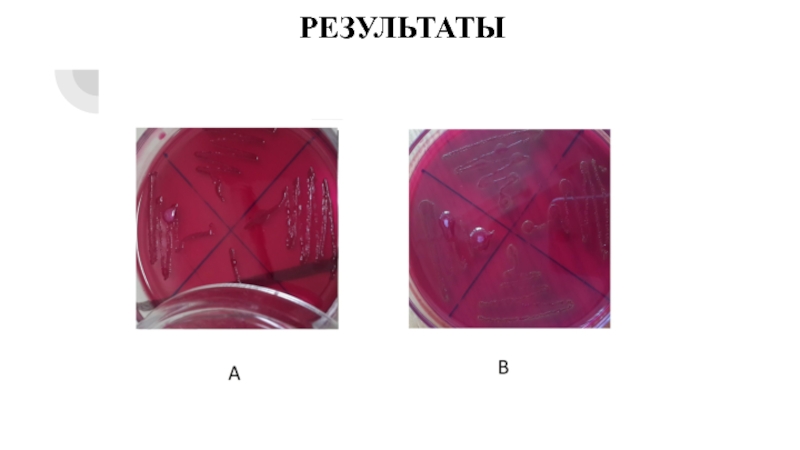

образования
ДАЛЬНЕВОСТОЧНЫЙ ФЕДЕРАЛЬНЫЙ УНИВЕРСИТЕТ
ШКОЛА ЕСТЕСТВЕННЫХ НАУК
МИКРОБИОЛОГИЧЕСКИЙ АНАЛИЗ ПИВА
(ИССЛЕДОВАНИЕ КАЧЕСТВА)
Выполнил: Луков
Евгений Иванович, гр. Б8308аРуководитель ВКР: Сидоренко Марина Леонидовна,
к.б.н., ст. н. с. сектора почвоведения и экологии почв ФНЦ
Биоразнообразия ДВО РАН